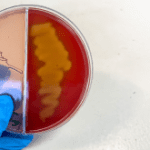
Module 1: Vaccine-Preventable Pneumonia Series: Not so sweet! Capsular polysaccharide type 3 and pneumococcal disease

Latest Module
Type 1 Diabetes – Practical approaches to insulin Gla-300 usage
SA paediatric experts present the clinical and real-world evidence on the use of insulin glargine-300 in Type 1 Diabetes Mellitus (T1DM)
When do I consider biologic therapy for a patient with severe asthma?
Biologics for symptomatic, poorly controlled asthma is a realistic option for these patients, says SA experts
Module 1: Vaccine-Preventable Pneumonia Series: Not so sweet! Capsular polysaccharide type 3 and pneumococcal disease
Prof G Richards, analyses the prevailing causes of pneumonia in South Africa